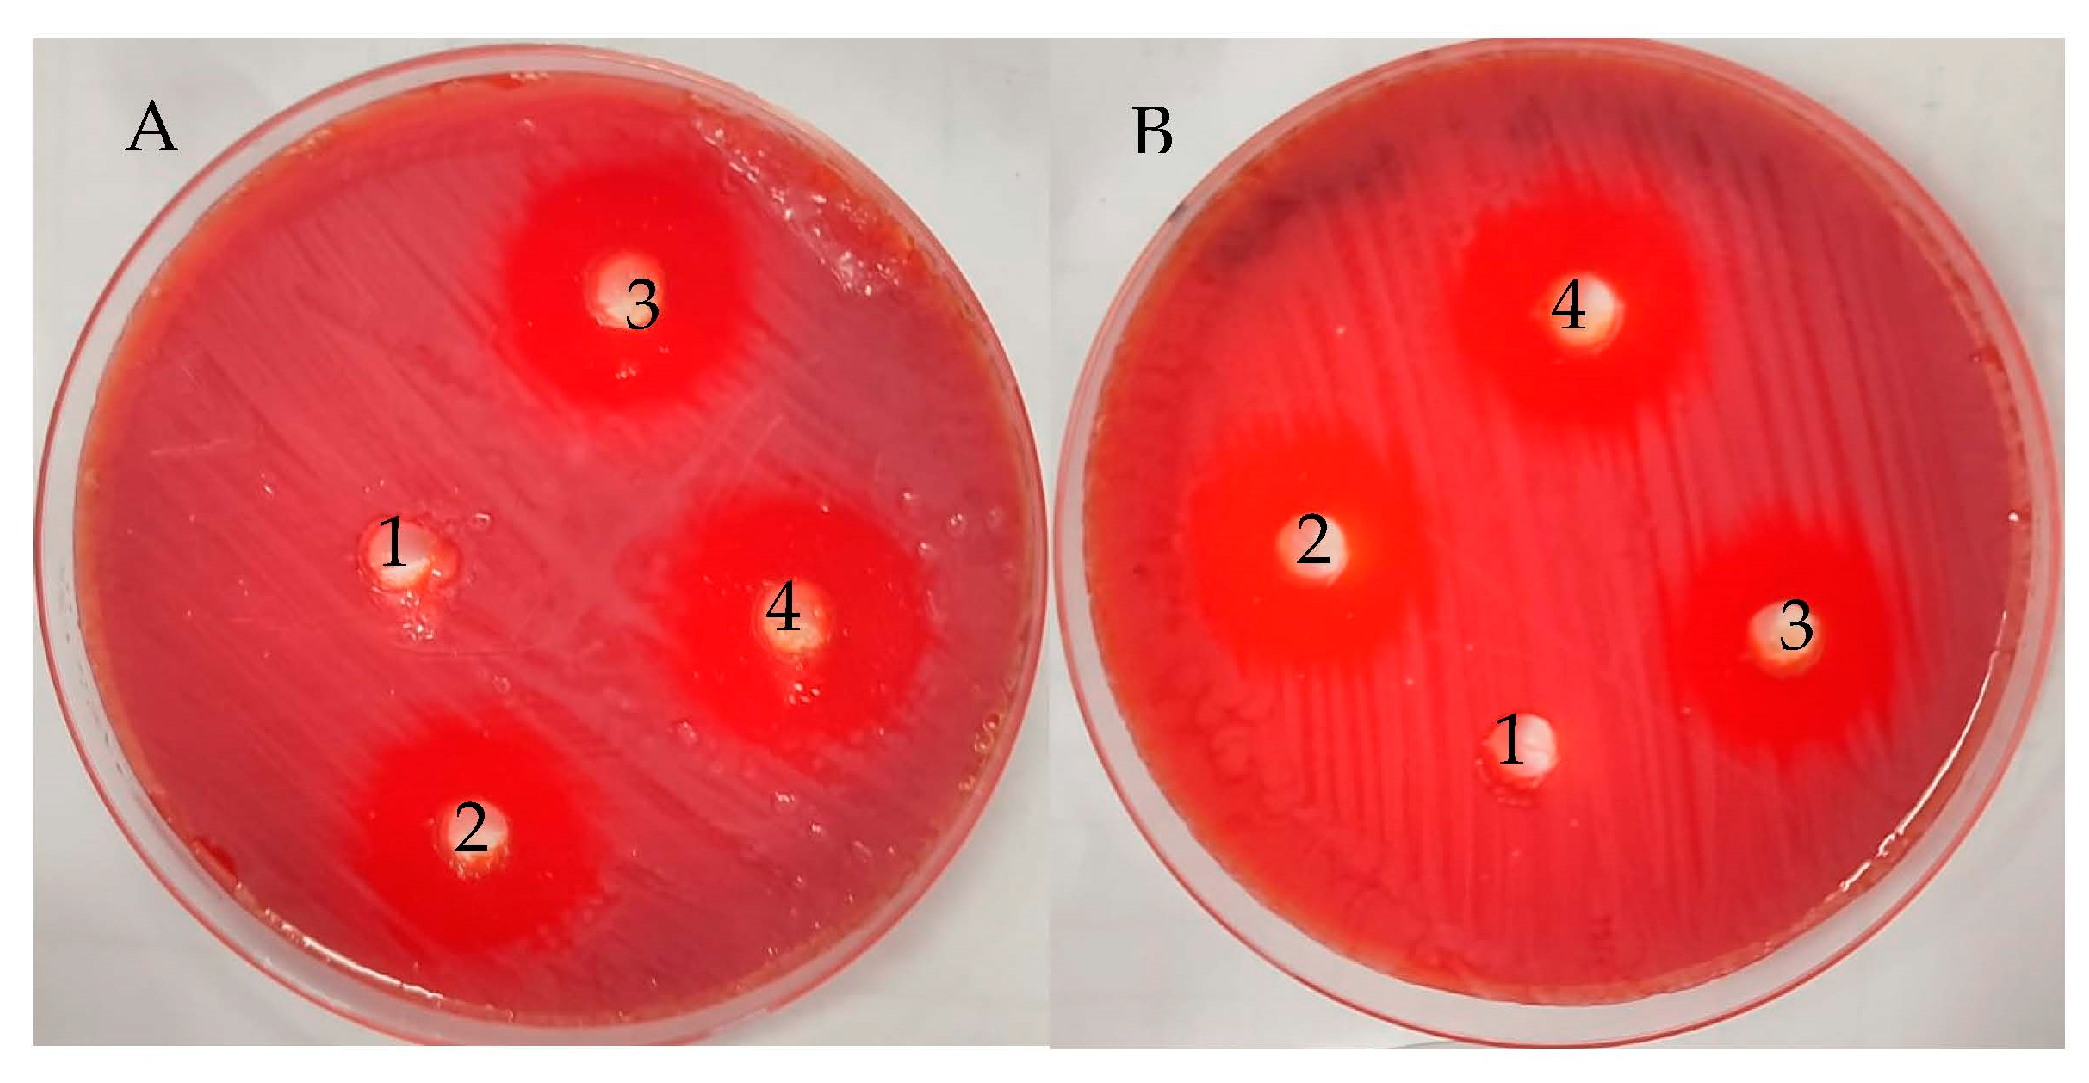
Life 13 01512 g004

Anti-Helicobacter pylori, Antioxidant, Antidiabetic, and Anti-Alzheimer’s Activities of Laurel Leaf Extract Treated by Moist Heat and Molecular Docking of Its Flavonoid Constituent, Naringenin, against Acetylcholinesterase and Butyrylcholinesterase
Abstract
1. Introduction
2. Materials and Methods
2.1. Chemical Used
2.2. Sample Collection and Effect of Moist Heat
2.3. HPLC Analysis of Phenolic and Flavonoid Contents of UMH and MH LLEs
2.4. Total Phenolic and Flavonoid Content Detection
2.5. Anti-H. pylori Activity of UMH and MH Extracts of L. nobilis Leaves
2.6. Assay of Minimal Inhibitory Concentration (MIC) and Minimal Bactericidal Concentration (MBC)
2.7. Anti-Biofilm Activity of UMH and MH LLEs
2.8. Urease Inhibition by UMH or MH LLE
2.9. DPPH Radical Scavenging Activity for Antioxidant Activity Assessment of UMH and MH LLEs
2.10. Assay of α-Glucosidase Inhibition by UMH and MH LLEs
2.11. Butyrylcholinesterase Inhibition Assay
2.12. Molecular Docking Investigation
2.13. Statistical Analysis
3. Results and Discussion
3.1. Phenolic and Flavonoid Characterization of LLEs
3.2. Anti-H. pylori Activity
3.3. Urease Inhibition
3.4. Antioxidant Activity
3.5. Antidiabetic Activity
3.6. Anti-Alzheimer’s Activity
3.7. Molecular Docking of Naringenin with Acetylcholinesterase and Butyrylcholinesterase
4. Conclusions
Author Contributions
Funding
Institutional Review Board Statement
Informed Consent Statement
Data Availability Statement
Acknowledgments
Conflicts of Interest
References
- Derwich, E.; Benziane, Z.; Boukir, A.; Mohamed, S.; Abdellah, B. Chemical composition and antibacterial activity of leaves essential oil of Laurus nobilis from Morocco. Aust. J. Basic Appl. Sci. 2009, 3, 3818–3824. [Google Scholar]
- Sakran, K.A.; Raharjo, D.; Mertaniasih, N.M. Antimicrobial Activities of Laurus nobilis Leaves Ethanol Extract on Staphylococcus aureus, Salmonellae typhi, and Escherichia coli. Indones. J. Trop. Infect. Dis. 2021, 9, 120–125. [Google Scholar] [CrossRef]
- Sırıken, B.; Yavuz, C.; Güler, A. Antibacterial Activity of Laurus nobilis: A review of literature. Med. Sci. Discov. 2018, 5, 374–379. [Google Scholar] [CrossRef]
- Mssillou, I.; Agour, A.; El Ghouizi, A.; Hamamouch, N.; Lyoussi, B.; Derwich, E. Chemical Composition, Antioxidant Activity, and Antifungal Effects of Essential Oil from Laurus nobilis L. Flowers Growing in Morocco. J. Food Qual. 2020, 2020, 8819311. [Google Scholar] [CrossRef]
- da Silveira, S.M.; Luciano, F.B.; Fronza, N.; Cunha, A., Jr.; Scheuermann, G.N.; Vieira, C.R.W. Chemical composition and antibacterial activity of Laurus nobilis essential oil towards foodborne pathogens and its application in fresh Tuscan sausage stored at 7 C. LWT-Food Sci. Technol. 2014, 59, 86–93. [Google Scholar] [CrossRef]
- Marques, A.; Teixeira, B.; Nunes, M.L. Bay laurel (Laurus nobilis) oils. In Essential Oils in Food Preservation, Flavor and Safety; Academic Press: Cambridge, MA, USA, 2016; pp. 239–246. [Google Scholar] [CrossRef]
- Mahmoud, S.H.; Wafa, M.M. The antibacterial activity of Laurus nobilis leaf extract and its potential use as a preservative for fresh lamb meat. Afr. J. Microbiol. Res. 2020, 14, 617–624. [Google Scholar] [CrossRef]
- De Corato, U.; Maccioni, O.; Trupo, M.; Di Sanzo, G. Use of essential oil of Laurus nobilis obtained by means of a supercritical carbon dioxide technique against post harvest spoilage fungi. Crop Prot. 2010, 29, 142–147. [Google Scholar] [CrossRef]
- Jemâa, J.M.B.; Tersim, N.; Toudert, K.T.; Khouja, M.L. Insecticidal activities of essential oils from leaves of Laurus nobilis L. from Tunisia, Algeria and Morocco, and comparative chemical composition. J. Stored Prod. Res. 2012, 48, 97–104. [Google Scholar] [CrossRef]
- Fidan, H.; Stefanova, G.; Kostova, I.; Stankov, S.; Damyanova, S.; Stoyanova, A.; Zheljazkov, V.D. Chemical Composition and Antimicrobial Activity of Laurus nobilis L. Essential Oils from Bulgaria. Molecules 2019, 24, 804. [Google Scholar] [CrossRef]
- Dahak, K.; Bouamama, H.; Benkhalti, F.; Taourirte, M. Drying methods and their implication on quality, quantity and antimicrobial activity of the essential oil of Laurus nobilis L. from Morocco. Online J. Biol. Sci. 2014, 14, 94–101. [Google Scholar] [CrossRef]
- Khodja, Y.K.; Dahmoune, F.; Madani, K.; Khettal, B. Conventional method and microwave drying kinetics of Laurus nobilis leaves: Effects on phenolic compounds and antioxidant activity. Braz. J. Food Technol. 2020, 23, e2019214. [Google Scholar] [CrossRef]
- Taban, A.; Saharkhiz, M.J.; Niakousari, M. Sweet bay (Laurus nobilis L.) essential oil and its chemical composition, antioxidant activity and leaf micromorphology under different extraction methods. Sustain. Chem. Pharm. 2018, 9, 12–18. [Google Scholar] [CrossRef]
- Yahya, R.; Al-Rajhi, A.M.H.; Alzaid, S.Z.; Al Abboud, M.A.; Almuhayawi, M.S.; Al Jaouni, S.K.; Selim, S.; Ismail, K.S.; Abdelghany, T.M. Molecular Docking and Efficacy of Aloe vera Gel Based on Chitosan Nanoparticles against Helicobacter pylori and Its Antioxidant and Anti-Inflammatory Activities. Polymers 2022, 14, 2994. [Google Scholar] [CrossRef] [PubMed]
- Al-Rajhi, A.M.H.; Qanash, H.; Bazaid, A.S.; Binsaleh, N.K.; Abdelghany, T.M. Pharmacological Evaluation of Acacia nilotica Flower Extract against Helicobacter pylori and Human Hepatocellular Carcinoma In Vitro and In Silico. J. Funct. Biomater. 2023, 14, 237. [Google Scholar] [CrossRef]
- Guzeldag, G.; Kadioglu, L.; Mercimek, A.; Matyar, F. Preliminary examination of herbal extracts on the inhibition of Helicobacter pylori. Afr. J. Tradit. Complement. Altern. Med. 2013, 11, 93–96. [Google Scholar]
- Qanash, H.; Bazaid, A.S.; Binsaleh, N.K.; Alharbi, B.; Alshammari, N.; Qahl, S.H.; Alhuthali, H.M.; Bagher, A.A. Phytochemical Characterization of Saudi Mint and Its Mediating Effect on the Production of Silver Nanoparticles and Its Antimicrobial and Antioxidant Activities. Plants 2023, 12, 2177. [Google Scholar] [CrossRef]
- Mashraqi, A.; Modafer, Y.; Al Abboud, M.A.; Salama, H.M.; Abada, E. HPLC Analysis and Molecular Docking Study of Myoporum serratum Seeds Extract with Its Bioactivity against Pathogenic Microorganisms and Cancer Cell Lines. Molecules 2023, 28, 4041. [Google Scholar] [CrossRef]
- Aldayel, T.S.; MBadran, M.; HAlomrani, A.; AlFaris, N.A.; ZAltamimi, J.; SAlqahtani, A.; ANasr, F.; Ghaffar, S.; Orfali, R. Chitosan-Coated Solid Lipid Nanoparticles as an Efficient Avenue for Boosted Biological Activities of Aloe perryi: Antioxidant, Antibacterial, and Anticancer Potential. Molecules 2023, 28, 3569. [Google Scholar] [CrossRef]
- Al-Rajhi, A.M.H.; Yahya, R.; Bakri, M.M.; Yahya, R.; Abdelghany, T.M. In situ green synthesis of Cu-doped ZnO based polymers nanocomposite with studying antimicrobial, antioxidant and anti-inflammatory activities. Appl. Biol. Chem. 2022, 65, 35. [Google Scholar] [CrossRef]
- Al-Rajhi, A.M.; Salem, S.S.; Alharbi, A.A.; Abdelghany, T.M. Ecofriendly synthesis of silver nanoparticles using Kei-apple (Dovyalis caffra) fruit and their efficacy against cancer cells and clinical pathogenic microorganisms. Arab. J. Chem. 2022, 15, 103927. [Google Scholar] [CrossRef]
- Qanash, H.; Yahya, R.; Bakri, M.M.; Bazaid, A.S.; Qanash, S.; Shater, A.F.; Abdelghany, T.M. Anticancer, antioxidant, antiviral and antimicrobial activities of Kei Apple (Dovyalis caffra) fruit. Sci. Rep. 2022, 12, 5914. [Google Scholar] [CrossRef]
- Baig, M.H.; Ahmad, K.; Rabbani, G.; Choi, I. Use of Peptides for the Management of Alzheimer’s Disease: Diagnosis and Inhibition. Front. Aging Neurosci. 2018, 10, 21. [Google Scholar] [CrossRef] [PubMed]
- Adedayo, B.C.; Oyeleye, S.I.; Okeke, B.M.; Oboh, G. Anti-cholinesterase and antioxidant properties of alkaloid and phenolic-rich extracts from pawpaw (Carica papaya) leaf: A comparative study. Flavour. Fragr. J. 2020, 36, 47–54. [Google Scholar] [CrossRef]
- Al-Rajhi, A.M.H.; Abdel Ghany, T.M. Nanoemulsions of some edible oils and their antimicrobial, antioxidant, and anti-hemolytic activities. BioResources 2023, 18, 1465–1481. [Google Scholar] [CrossRef]
- Andrews, J.M. Determination of minimum inhibitory concentrations. J. Antimicrob. Chemother. 2001, 48 (Suppl. S1), 5–16. [Google Scholar] [CrossRef]
- French, G.L. Bactericidal Agents in the Treatment of MRSA Infections—The Potential Role of Daptomycin. J. Antimicrob. Chemother. 2006, 58, 1107. [Google Scholar] [CrossRef]
- Antunes, A.L.S.; Trentin, D.S.; Bonfanti, J.W.; Pinto, C.C.F.; Perez, L.R.R.; Macedo, A.J.; Barth, A.L. Application of a feasible method for determination of biofilm antimicrobial susceptibility in staphylococci. Acta Patol. Microbiol. Immunol. Scand. 2010, 118, 873–877. [Google Scholar] [CrossRef]
- Mahernia, S.; Bagherzadeh, K.; Mojab, F.; Amanlou, M. Urease Inhibitory Activities of some Commonly Consumed Herbal Medicines. Iran. J. Pharm. Res. 2015, 14, 943–947. [Google Scholar]
- Al-Rajhi, A.M.H.; Yahya, R.; Abdelghany, T.M.; Fareid, M.A.; Mohamed, A.M.; Amin, B.H.; Masrahi, A.S. Anticancer, Anticoagulant, Antioxidant and Antimicrobial Activities of Thevetia peruviana Latex with Molecular Docking of Antimicrobial and Anticancer Activities. Molecules 2022, 27, 3165. [Google Scholar] [CrossRef] [PubMed]
- Pistia-Brueggeman, G.; Hollingsworth, R.I. A preparation and screening strategy for glycosidase inhibitors. Tetrahedron 2001, 57, 8773–8778. [Google Scholar] [CrossRef]
- Ellman, G.L.; Courtney, K.D.; Andres, V., Jr.; Feather-Stone, R.M. A new and rapid colorimetric determination of acetylcholinesterase activity. Biochem. Pharmacol. 1961, 7, 88–95. [Google Scholar] [CrossRef] [PubMed]
- Sezgin, Z.; Biberoglu, K.; Chupakhin, V.; Makhaeva, G.F.; Tacal, O. Determination of binding points of methylene blue and cationic phenoxazine dyes on human butyrylcholinesterase. Arch. Biochem. Biophys. 2013, 532, 32–38. [Google Scholar] [CrossRef] [PubMed]
- Juániz, I.; Ludwig, I.A.; Huarte, E.; Pereira-Caro, G.; Moreno-Rojas, J.M.; Cid, C.; De Peña, M.P. Influence of heat treatment on antioxidant capacity and (poly)phenolic compounds of selected vegetables. Food Chem. 2016, 197 Pt A, 66–73. [Google Scholar] [CrossRef]
- Routray, W.; Orsat, V. Microwave-Assisted Extraction of Flavonoids: A Review. Food Bioprocess Technol. 2012, 5, 409–424. [Google Scholar] [CrossRef]
- Dobroslavić, E.; Elez Garofulić, I.; Zorić, Z.; Pedisić, S.; Dragović-Uzelac, V. Polyphenolic Characterization and Antioxidant Capacity of Laurus nobilis L. Leaf Extracts Obtained by Green and Conventional Extraction Techniques. Processes 2021, 9, 1840. [Google Scholar] [CrossRef]
- Ramos, C.; Teixeira, B.; Batista, I.; Matos, O.; Serrano, C.; Neng, N.R.; Nogueira, J.M.F.; Nunes, M.L.; Marques, A. Antioxidant and antibacterial activity of essential oil and extracts of bay laurel Laurus nobilis Linnaeus (Lauraceae) from Portugal. Nat. Prod. Res. 2012, 26, 518–529. [Google Scholar] [CrossRef]
- Bulut Kocabas, B.; Attar, A.; Peksel, A.; Altikatoglu Yapaoz, M. Phytosynthesis of CuONPs via Laurus nobilis: Determination of antioxidant content, antibacterial activity, and dye decolorization potential. Biotechnol. Appl. Biochem. 2021, 68, 889–895. [Google Scholar] [CrossRef]
- Alejo-Armijo, A.; Altarejos, J.; Salido, S. Phytochemicals and biological activities of laurel tree (Laurus nobilis). Nat. Prod. Commun. 2017, 12, 743–757. [Google Scholar] [CrossRef]
- Muñiz-Márquez, D.B.; Rodríguez, R.; Balagurusamy, N.; Carrillo, M.L.; Belmares, R.; Contreras, J.C.; Nevárez, G.V.; Aguilar, C.N. Phenolic content and antioxidant capacity of extracts of Laurus nobilis L., Coriandrum sativum L. and Amaranthus hybridus L. CyTA-J. Food 2014, 12, 271–276. [Google Scholar] [CrossRef]
- Dobroslavić, E.; Repajić, M.; Dragović-Uzelac, V.; Elez Garofulić, I. Isolation of Laurus nobilis Leaf Polyphenols: A Review on Current Techniques and Future Perspectives. Foods 2022, 11, 235. [Google Scholar] [CrossRef]
- Martini, S.; D’Addario, C.; Colacevich, A.; Focardi, S.; Borghini, F.; Santucci, A.; Figura, N.; Rossi, C. Antimicrobial activity against Helicobacter pylori strains and antioxidant properties of blackberry leaves (Rubus ulmifolius) and isolated compounds. Int. J. Antimicrob. Agents 2009, 34, 50–59. [Google Scholar] [CrossRef] [PubMed]
- Duda-Madej, A.; Stecko, J.; Sobieraj, J.; Szymańska, N.; Kozłowska, J. Naringenin and Its Derivatives—Health-Promoting Phytobiotic against Resistant Bacteria and Fungi in Humans. Antibiotics 2022, 11, 1628. [Google Scholar] [CrossRef] [PubMed]
- Bae, E.A.; Han, M.J.; Kim, D.H. In vitro anti-Helicobacter pylori activity of some flavonoids and their metabolites. Planta Med. 1999, 65, 442–443. [Google Scholar] [CrossRef] [PubMed]
- Widelski, J.; Okińczyc, P.; Suśniak, K.; Malm, A.; Bozhadze, A.; Jokhadze, M.; Korona-Głowniak, I. Correlation between Chemical Profile of Georgian Propolis Extracts and Their Activity against Helicobacter pylori. Molecules 2023, 28, 1374. [Google Scholar] [CrossRef] [PubMed]
- Biglar, M.; Sufi, H.; Bagherzadeh, K.; Amanlou, M.; Mojab, F. Screening of 20 commonly used Iranian traditional medicinal plants against urease. Iran. J. Pharm. Res. 2014, 13, 195–198. [Google Scholar]
- Papageorgiou, V.; Mallouchos, A.; Komaitis, M. Investigation of the antioxidant behavior of air- and freeze-dried aromatic plant materials in relation to their phenolic content and vegetative cycle. J. Agric. Food Chem. 2008, 56, 5743–5752. [Google Scholar] [CrossRef]
- Mohammed, R.R.; Omer, A.K.; Yener, Z.; Uyar, A.; Ahmed, A.K. Biomedical effects of Laurus nobilis L. leaf extract on vital organs in streptozotocin-induced diabetic rats: Experimental research. Ann. Med. Surg. 2020, 61, 188–197. [Google Scholar] [CrossRef]
- Khan, I.; Shah, S.; Ahmad, J.; Abdullah, A.; Johnson, S.K. Effect of incorporating Bay leaves in cookies on postprandial glycemia, appetite, palatability, and gastrointestinal well-being. J. Am. Coll. Nutr. 2017, 36, 514–519. [Google Scholar] [CrossRef]
- Duletić-Laušević, S.; Oalđe, M.; Alimpić-Aradski, A. In vitro evaluation of antioxidant, antineurodegenerative and antidiabetic activities of Ocimum basilicum L., Laurus nobilis L. leaves and Citrus reticulata Blanco peel extracts. Lek. Sirovine 2019, 39, 60–68. [Google Scholar] [CrossRef]
- Li, Y.Q.; Zhou, F.C.; Gao, F.; Bian, J.S.; Shan, F. Comparative evaluation of quercetin, isoquercetin and rutin as inhibitors of alpha-glucosidase. J. Agric. Food Chem. 2009, 57, 11463–11468. [Google Scholar] [CrossRef]
- Shen, H.; Wang, J.; Ao, J.; Cai, Y.; Xi, M.; Hou, Y.; Luo, A. Inhibitory kinetics and mechanism of active compounds in green walnut husk against α-glucosidase: Spectroscopy and molecular docking analyses. LWT 2022, 172, 114179. [Google Scholar] [CrossRef]
- Falade, A.O.; Omolaiye, G.I.; Adewole, K.E.; Agunloye, O.M.; Ishola, A.A.; Okaiyeto, K.; Oboh, G.; Oguntibeju, O.O. Aqueous Extracts of Bay Leaf (Laurus nobilis) and Rosemary (Rosmarinus officinalis) Inhibit Iron-Induced Lipid Peroxidation and Key-Enzymes Implicated in Alzheimer’s Disease in Rat Brain-in Vitro. Am. J. Biochem. Biotechnol. 2022, 18, 9–22. [Google Scholar] [CrossRef]
- Banpure, S.G.; Chopade, V.V.; Chaudhari, P.D. Anti-Alzhimer Activity of Bay Leaves in Scopolamineinduced Rat Model. J. Drug Deliv. Technol. 2023, 13, 17–22. [Google Scholar] [CrossRef]
- Dehghan, M.; Fathinejad, F.; Farzaei, M.H.; Barzegari, E. In silico unraveling of molecular anti-neurodegenerative profile of Citrus medica flavonoids against novel pharmaceutical targets. Chem. Pap. 2023, 77, 595–610. [Google Scholar] [CrossRef]
- Qanash, H.; Alotaibi, K.; Aldarhami, A.; Bazaid, A.S.; Ganash, M.; Saeedi, N.H.; Ghany, T.A. Effectiveness of oil-based nanoemulsions with molecular docking of its antimicrobial potential. BioResources 2023, 18, 1554–1576. [Google Scholar] [CrossRef]

| Compound | UMH Laurel Leaf Extract | MH Laurel Leaf Extract | ||||||
|---|---|---|---|---|---|---|---|---|
| Retention Time | Area | Area (%) | Conc. (µg/mL) | Retention Time | Area | Area (%) | Conc. (µg/mL) | |
| Gallic acid | 3.34 | 332.50 | 7.68 | 1435.58 | 3.339 | 325.41 | 6.79 | 1405.00 |
| Chlorogenic acid | 3.97 | 169.05 | 3.90 | 1157.51 | 4.169 | 0.00 | 0.00 | 0.00 |
| Catechin | 4.53 | 266.21 | 6.15 | 3296.24 | 4.516 | 260.61 | 5.44 | 3226.94 |
| Methyl gallate | 5.44 | 1268.23 | 29.30 | 3461.19 | 5.427 | 1453.81 | 30.34 | 3967.65 |
| Caffeic acid | 6.22 | 51.22 | 1.18 | 196.96 | 6.199 | 58.46 | 1.22 | 224.80 |
| Syringic acid | 6.57 | 83.73 | 1.93 | 283.90 | 6.528 | 0.00 | 0.00 | 0.00 |
| Pyrocatechol | 6.72 | 0.00 | 0.00 | 0.00 | 6.660 | 120.75 | 2.52 | 868.77 |
| Rutin | 8.02 | 114.38 | 2.64 | 664.12 | 8.002 | 152.91 | 3.19 | 887.83 |
| Ellagic acid | 8.53 | 305.87 | 7.06 | 2835.09 | 8.517 | 321.42 | 6.71 | 2979.14 |
| Coumaric acid | 9.04 | 97.16 | 2.24 | 153.26 | 9.003 | 128.70 | 2.69 | 203.02 |
| Vanillin | 9.77 | 116.26 | 2.69 | 254.43 | 9.750 | 130.07 | 2.71 | 284.65 |
| Ferulic acid | 10.31 | 469.84 | 10.85 | 1605.00 | 10.307 | 554.34 | 11.57 | 1893.66 |
| Naringenin | 10.68 | 744.04 | 17.19 | 4486.02 | 10.673 | 938.07 | 19.58 | 5655.89 |
| Daidzein | 12.24 | 10.24 | 0.24 | 31.64 | 12.312 | 0.00 | 0.00 | 0.00 |
| Quercetin | 12.80 | 110.03 | 2.54 | 757.79 | 12.782 | 60.99 | 1.27 | 420.02 |
| Cinnamic acid | 14.12 | 46.96 | 1.08 | 43.25 | 14.102 | 55.61 | 1.16 | 51.22 |
| Apigenin | 14.68 | 23.27 | 0.54 | 88.55 | 14.655 | 24.97 | 0.52 | 95.03 |
| Kaempferol | 15.12 | 53.38 | 1.23 | 206.95 | 15.298 | 141.13 | 2.95 | 547.19 |
| Hesperetin | 15.75 | 67.11 | 1.55 | 195.60 | 15.731 | 64.46 | 1.35 | 187.88 |
| Total phenol | 1.87 ± 0.33 mg GAE/g | 2.65 ± 0.17 mg GAE/g | ||||||
| Total flavonoid | 0.68 ± 0.10 mg QE/g | 1.05 ± 0.10 mg QE/g | ||||||
| Mean Inhibition Zone (mm) | MIC (µg/mL) | MBC (µg/mL) | MBC/MIC Index | ||||||
|---|---|---|---|---|---|---|---|---|---|
| UMH | MH | Control | Negative | UMH | MH | UMH | MH | UMH | MH |
| 23.67 ± 0.58 | 26.00 ± 0.0 | 20.33 ± 0.58 | 0.0 ± 0.0 | 7.8 ± 0.1 | 1.9 ± 0.17 | 7.8 ± 0.35 | 1.9 ± 0.1 | 1.0 | 1.0 |
| Concentration (µg/mL) | Ascorbic Acid | UMH LLE | MH LLE |
|---|---|---|---|
| DPPH Scavenging % | DPPH Scavenging % | DPPH Scavenging % | |
| 1000 | 97.0 ±0.004 | 95.5 ± 0.003 | 97.1 ± 0.006 |
| 500 | 94.2 ± 0.001 | 93.3 ± 0.001 | 94.7 ± 0.001 |
| 250 | 90.0 ± 0.004 | 87.6 ± 0.005 | 90.3 ± 0.003 |
| 125 | 83.1 ± 0.004 | 81.7 ± 0.002 | 85.2 ± 0.005 |
| 62.50 | 76.4 ± 0.004 | 75.6 ± 0.003 | 77.7 ± 0.003 |
| 31.25 | 69.3 ± 0.002 | 68.9 ± 0.003 | 71.0 ± 0.006 |
| 15.63 | 62.5 ± 0.003 | 61.80.003 | 64.5 ± 0.004 |
| 7.81 | 55.2 ± 0.002 | 54.6 ± 0.004 | 57.8 ± 0.004 |
| 3.90 | 48.3 ± 0.002 | 47.6 ± 0.003 | 50.5 ± 0.007 |
| 1.95 | 40.2 ± 0.002 | 39.9 ± 0.004 | 42.1 ± 0.002 |
| 0 | 0.0 ± 0.000 | 0.0 ± 0.000 | 0.0 ± 0.000 |
| IC50 | 4.43 µg/mL | 4.69 µg/mL | 3.45 µg/mL |
| Mol | rseq | mseq | S | rmsd_refine | E_conf | E_place | E_score1 | E_refine | E_score2 |
|---|---|---|---|---|---|---|---|---|---|
| Naringenin | 1 | 1 | −6.78716 | 0.978201 | −39.4713 | −76.5186 | −13.1741 | −36.5393 | −6.78716 |
| Naringenin | 1 | 1 | −6.67799 | 1.277979 | −34.1638 | −68.3821 | −12.2916 | −36.1206 | −6.67799 |
| Naringenin | 1 | 1 | −6.62979 | 1.202798 | −40.401 | −90.799 | −12.9332 | −38.2054 | −6.62979 |
| Naringenin | 1 | 1 | −6.58196 | 0.838779 | −33.5025 | −72.8311 | −12.7582 | −35.0069 | −6.58196 |
| Naringenin | 1 | 1 | −6.55275 | 1.554429 | −39.5703 | −71.615 | −12.3801 | −32.3347 | −6.55275 |
| Mol | rseq | mseq | S | rmsd_refine | E_conf | E_place | E_score1 | E_refine | E_score2 |
|---|---|---|---|---|---|---|---|---|---|
| Naringenin | 1 | 1 | −6.14549 | 0.733427 | −39.739 | −86.8222 | −11.8804 | −26.7900 | −6.14549 |
| Naringenin | 1 | 1 | −6.02164 | 1.344088 | −38.5364 | −65.6819 | −11.5795 | −26.8067 | −6.02164 |
| Naringenin | 1 | 1 | −5.88513 | 0.995142 | −39.3925 | −65.6398 | −11.7741 | −26.4780 | −5.88513 |
| Naringenin | 1 | 1 | −5.81087 | 1.068273 | −37.007 | −80.6394 | −12.5956 | −27.5993 | −5.81087 |
| Naringenin | 1 | 1 | −5.74699 | 1.258355 | −37.1225 | −74.7382 | −12.0082 | −24.9304 | −5.74699 |
| Mol | Ligand | Receptor | Interaction | Distance | E (kcal/mol) |
|---|---|---|---|---|---|
| Naringenin | O 29 | O TYR 70 (A) | H-donor | 2.81 | −2.7 |
| O 31 | O HIS 440 (A) | H-donor | 2.82 | −3.3 |
| Mol | Ligand | Receptor | Interaction | Distance | E (kcal/mol) |
|---|---|---|---|---|---|
| Naringenin | O 29 | 5-ring TRP 430 (A) | H-Pi | 4.03 | −0.6 |
Disclaimer/Publisher’s Note: The statements, opinions and data contained in all publications are solely those of the individual author(s) and contributor(s) and not of MDPI and/or the editor(s). MDPI and/or the editor(s) disclaim responsibility for any injury to people or property resulting from any ideas, methods, instructions or products referred to in the content. |
© 2023 by the authors. Licensee MDPI, Basel, Switzerland. This article is an open access article distributed under the terms and conditions of the Creative Commons Attribution (CC BY) license (https://creativecommons.org/licenses/by/4.0/).
Share and Cite
Al-Rajhi, A.M.H.; Qanash, H.; Almashjary, M.N.; Hazzazi, M.S.; Felemban, H.R.; Abdelghany, T.M. Anti-Helicobacter pylori, Antioxidant, Antidiabetic, and Anti-Alzheimer’s Activities of Laurel Leaf Extract Treated by Moist Heat and Molecular Docking of Its Flavonoid Constituent, Naringenin, against Acetylcholinesterase and Butyrylcholinesterase. Life 2023, 13, 1512. https://doi.org/10.3390/life13071512
Al-Rajhi AMH, Qanash H, Almashjary MN, Hazzazi MS, Felemban HR, Abdelghany TM. Anti-Helicobacter pylori, Antioxidant, Antidiabetic, and Anti-Alzheimer’s Activities of Laurel Leaf Extract Treated by Moist Heat and Molecular Docking of Its Flavonoid Constituent, Naringenin, against Acetylcholinesterase and Butyrylcholinesterase. Life. 2023; 13(7):1512. https://doi.org/10.3390/life13071512
Chicago/Turabian StyleAl-Rajhi, Aisha M. H., Husam Qanash, Majed N. Almashjary, Mohannad S. Hazzazi, Hashim R. Felemban, and Tarek M. Abdelghany. 2023. "Anti-Helicobacter pylori, Antioxidant, Antidiabetic, and Anti-Alzheimer’s Activities of Laurel Leaf Extract Treated by Moist Heat and Molecular Docking of Its Flavonoid Constituent, Naringenin, against Acetylcholinesterase and Butyrylcholinesterase" Life 13, no. 7: 1512. https://doi.org/10.3390/life13071512
APA StyleAl-Rajhi, A. M. H., Qanash, H., Almashjary, M. N., Hazzazi, M. S., Felemban, H. R., & Abdelghany, T. M. (2023). Anti-Helicobacter pylori, Antioxidant, Antidiabetic, and Anti-Alzheimer’s Activities of Laurel Leaf Extract Treated by Moist Heat and Molecular Docking of Its Flavonoid Constituent, Naringenin, against Acetylcholinesterase and Butyrylcholinesterase. Life, 13(7), 1512. https://doi.org/10.3390/life13071512

